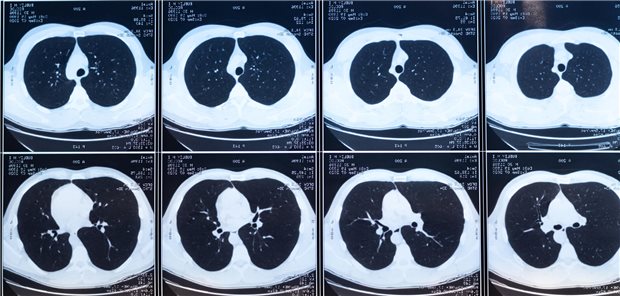
Warum das Screening auf Lungenkrebs für die HNO-Medizin interessant ist Aufnahmen einer CT-Untersuchungen der Lunge zur Diagnose einer möglichen Lungenerkrankungen.

Erste Auswertung
Sozialmedizinisches Gespräch zeigt Wirkung
Seit Juli 2014 sorgt eine Vereinbarung der KV Mecklenburg-Vorpommern (KVMV) und der AOK Nordost dafür, dass das ausführliche sozialmedizinische Gespräch Hausärzten auch dann vergütet wird, wenn keine Erkrankung vorliegt.
Erste Auswertungen der KVMV belegen die Wirksamkeit des innovativen Versorgungsvertrages im Land. Die Selbstkompetenz und Therapietreue der Patienten werde gefördert, weil notwendige ärztliche und pflegerische Maßnahmen erörtert bzw. koordiniert werden, so die KVMV.
Außerdem könnten durch die intensive Kommunikation bereits frühzeitig vorliegende psychosomatische Erkrankungen erkannt werden.